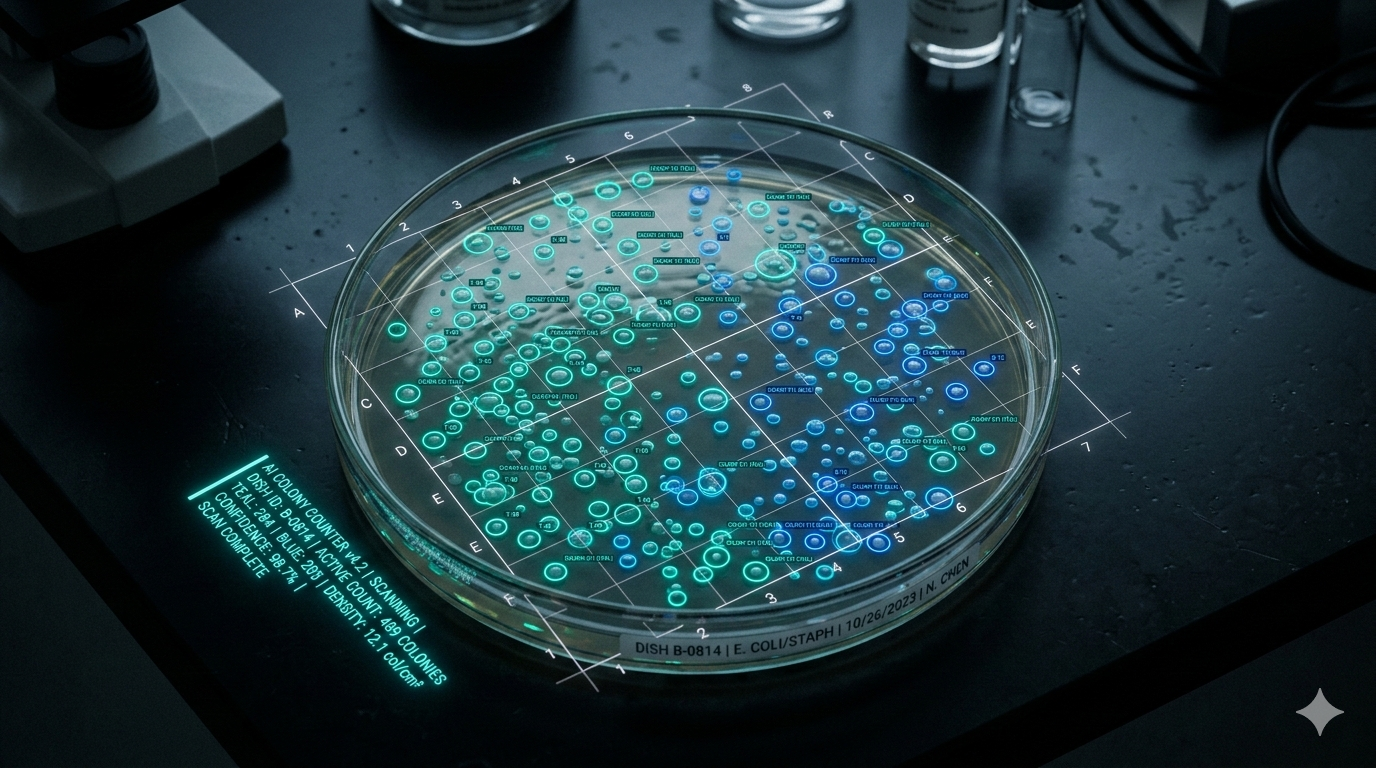
Bacterial Colony Counter

Try Before You Talk
No signup. No credit card. Just useful tools built by a research scientist for researchers and food businesses.
Bacterial Colony Counter
Upload petri dish images and get instant AI-powered colony counts with computer vision analysis. 90%+ accuracy.
Need batch processing for your full workflow? See what we build → Try It Free → Popular
Microglia Morphology Analyzer
Upload microscopy images for instant cell classification — solidity, area, and morphological state. 95% accuracy.
Need this integrated into your analysis pipeline? See what we build → Try It Free → New
FoodCost Pro Calculator
Calculate true product costs including ingredients, labor, packaging & overhead with pricing recommendations.
Need multi-SKU costing with supplier sync? See what we build → Get Free Access → New
FSMA 204 Compliance Checker
Answer 6 questions to find out if the FDA Food Traceability Rule applies to your business. Enforcement live January 2026.
Need a full traceability AI system? See what we build → Check Now →
AI Food Scientist
Ask about recipe optimization, ingredient substitutions, or nutraceutical formulation. Instant answers.
Need a custom AI for your R&D team? See what we build → Chat Now →


